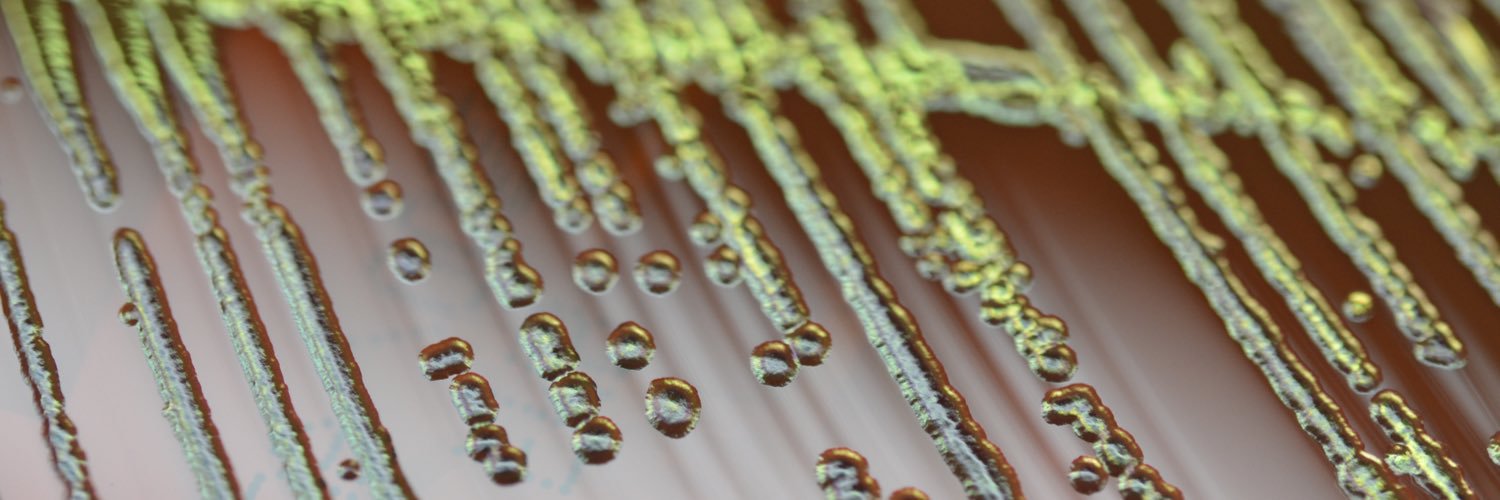
Rachael Liesman banner

Rachael Liesman
40 posts

Rachael Liesman
@MidwestMicrobes
Clinical microbiologist, amateur baker.
Katılım Mart 2018
165 Takip Edilen344 Takipçiler

Rachael Liesman retweetledi

Registration is open!! The program features practical presentations, engaging debate sessions, and professional development opportunities along the white sand beaches of Clearwater Beach, FL. Attend in-person or virtually! Register at pascv.org/mvw. #mvw23

English

@LABRAT270 Cherry jello, grape and strawberry Nerds, and Gushers candy! The Nerds slowly melted over time which made the colonies more ‘mucoid’.
English

@MidwestMicrobes Which edible objects have you incorporated? Red jello , green maraschino Cherry and ??
English

@DavidCGaston Can’t ship plates. Will make you a slant. 😂
English

@MidwestMicrobes That is fantastic! How well would those keep if shipped to Nashville?
English
Rachael Liesman retweetledi

What are the challenges and limitations of implementing quantitative molecular tests? Join molecular virology laboratory experts for informal and interactive discussions around quantitative viral molecular testing at #PASCVFall22. Secure your spot today! pascv.org/page/FallRegis…

English
Rachael Liesman retweetledi

Join us at the SWACM annual meeting September 7-9 in Kansas City! We have an excellent speaker lineup. Full program and registration available at SWACM.org. @SWACM1 @MidwestMicrobes @DrMattBinnicker @ali_eberly @MMBhattiMD @MicroMeIanie

English

Please remember to collect at least four hot sauce bottles for optimal blood culture sensitivity! 😂🤣
Corynn Kasap@corynnkasap
A family member admitted to the hospital for IV antibiotics just told me the RN took "2 hot sauce bottles of blood" which is how i will be referring to blood cultures from now on.
English

Not pictured: breakfast from our fantastic ID colleagues. Happy lab week and thank you for supporting the lab year-round! @KUInfectDisease @KUIDfellowship
English

Lab week treats from our favorite Infection Prevention and Control friends! Teamwork makes the dream work! @maggie_reavis @tiffany_horsley @lancescot

English

Look at these tiny squiggles!
Helicobacter cinaedi from a blood cx
Spirals or gull wings on BCx Gram? Incubate microaerophilic at 42 AND 37oC. Helicobacter and some Campy only grow at 37.
#MicroRounds

English

@DrMattBinnicker @KarissaPhD @KatherineJWu Everything I know about clinical virology, I learned from @DrMattBinnicker, @EmilyFern5 and the rest of the incredible Mayo clinical virology team.
English

I love my profession and the daily opportunity to help others.
But I love my colleagues even more, and reading these stories makes me really proud to know them. @KarissaPhD @MidwestMicrobes @KatherineJWu
nytimes.com/2020/12/03/hea…
Minnesota, USA 🇺🇸 English


We soldier on "out of sheer will of not wanting to be beaten by this"
Ain't that the truth...
Thanks to the hardworking resilient tired lab professionals who have been at this 24/7 since March.
And thanks @KatherineJWu for seeing and telling this story
nytimes.com/2020/12/03/hea…
English

@SBtotheDub @richdavisphd OMG I remember the panic I felt hearing him say that. We weren’t even live with in house testing at that point.
GIF
English

@richdavisphd “Anybody that wants a test can get a test” DJ Trump, March 6, 2020 - load of rubbish....
English

Thread of some phrases that have lodged into the psyches of our COVID times.
For me, it's Nancy Messonnier from the CDC: "We as a family ought to be preparing for significant disruption to our lives." - February 24, 2020
Kai Kupferschmidt@kakape
Question to my colleagues and the twitterverse in general: Looking back at these past 11 months, what are key quotes about #covid19, the pandemic and the response that have really stuck with you? Any language will do (if you give a translation).
English

@richdavisphd Me, trying to figure out if the aliquot tubes we just bought will fit on the instrument after the previous 6 we’ve used are all unavailable due to backorders:
GIF
English


